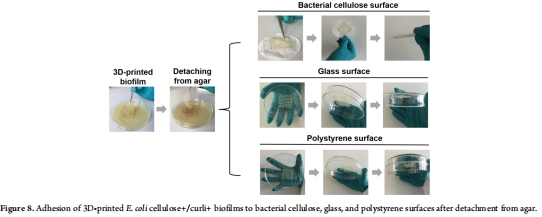

熱線:021-66110810,66110819
手機:13564362870

熱線:021-66110810,66110819
手機:13564362870
Emergent Biological Endurance Depends on Extracellular Matrix Composition of Three-Dimensionally Printed Escherichia coli Biofilms
緊急生物耐力取決于三維打印的大腸桿菌生物膜的細胞外基質組成
來源: American Chemical Society Synthetic Biology 2021, 10, 2997?3008
1. 摘要核心內容
本研究通過3D生物打印技術構建了具有可控胞外基質組成的大腸桿菌生物膜模型,探究了生物膜基質成分(纖維素與卷曲菌毛)對生物學耐受性(如消毒劑抗性)和空間氧分布的影響。研究發現:
基質成分決定耐受性:表達卷曲菌毛(Curli)的3D打印生物膜對乙醇和Virkon S消毒劑的抗性顯著高于僅含纖維素或不含基質的生物膜(圖5)。

氧擴散受限機制:卷曲菌毛的存在導致生物膜深層形成缺氧區(厚度達300-400 μm),模擬了天然生物膜的氧梯度特征(圖4)。

物理穩定性:3D打印生物膜可逆附著于細菌纖維素、玻璃等表面,抗物理形變(折疊/扭曲后恢復原狀),具備工程應用潛力(圖8)。
2. 研究目的
探究生物膜胞外基質組成(纖維素與卷曲菌毛)如何影響其:
生物學耐受性(消毒劑抗性);
空間氧分布模式;
物理穩定性,為設計功能性生物材料(如益生菌涂層、生物修復材料)提供理論依據。
3. 研究思路
3D打印+基質成分調控→表型分析:
菌株設計:使用三類大腸桿菌(表1):

同時表達纖維素和卷曲菌毛(Cellulose?/Curli?);
僅表達卷曲菌毛(Cellulose?/Curli?);
無基質成分(Cellulose?/Curli?)。
3D打印:定制生物墨水(海藻酸鈉+菌體),打印多層條紋結構(圖3)。

表型檢測:
消毒劑抗性:乙醇/Virkon S處理后檢測存活菌落(圖5);
氧分布:Unisense微電極測量生物膜內部氧濃度剖面(圖4);
物理穩定性:附著能力與抗形變測試(圖8)。
4. 關鍵數據及研究意義
(1)消毒劑抗性(圖5)
數據:Cellulose?/Curli?生物膜在70%乙醇處理下存活率最高(僅降低1.5-3 log),顯著優于Cellulose?/Curli?(降低3-5 log)和無基質組(降低5-6 log)。
意義:首次證明卷曲菌毛是消毒劑抗性的關鍵決定因子,而非纖維素。為設計抗消毒劑的工程生物膜提供靶點。
(2)氧分布剖面(圖4)
數據:Unisense微電極顯示:
Cellulose?/Curli?和Cellulose?/Curli?生物膜在200 μm深度處氧濃度降至0,形成厚缺氧區(300-400 μm);
無基質組(Cellulose?/Curli?)氧可滲透至底部(400 μm)。
意義:卷曲菌毛通過物理阻礙氧擴散(非代謝消耗)創造缺氧微環境,模擬天然生物膜的生理異質性。
(3)物理穩定性(圖8)
數據:3D打印生物膜可逆附著于細菌纖維素、玻璃、聚苯乙烯表面,折疊/扭曲后恢復原狀。
意義:證明其作為可移植生物材料的潛力(如醫療設備涂層)。
5. 核心結論
卷曲菌毛主導耐受性:是消毒劑抗性的主要決定因素,纖維素可能削弱其保護作用。
缺氧區由基質物理特性決定:卷曲菌毛通過限制氧擴散(非細胞代謝)形成深層缺氧區。
3D打印生物膜的應用潛力:可逆附著、抗形變特性支持其在益生菌涂層、生物修復等領域的應用。
6. 丹麥Unisense電極的研究意義
技術原理與優勢:
微電極氧傳感:50 μm尖端分辨率,實時測量生物膜內部氧濃度梯度(方法部分)。
高空間精度:以50-100 μm步長掃描剖面,精準定位缺氧區邊界(圖4)。
關鍵科學貢獻:
揭示基質物理屏障作用:
Unisense數據顯示:卷曲菌毛的存在使氧在200 μm深度驟降至0(圖4),直接證明其通過增加基質密度(物理擴散屏障)——而非細胞耗氧——導致缺氧。
量化生物膜生理異質性:
測得Cellulose?/Curli?生物膜缺氧區厚度(400 μm)顯著大于無基質組(0 μm),為“基質驅動氧限制”理論提供直接證據。
支撐耐受性機制:缺氧區與消毒劑抗性正相關(圖5),提示缺氧微環境可能是耐受性的誘因之一。
領域突破性價值:
克服傳統終點法(如切片染色)的破壞性局限,實現原位、動態監測生物膜微環境;
為合成生物學設計仿生生物膜(如可控缺氧材料)提供定量優化參數。
注:Unisense電極是本研究的核心技術,其高分辨率數據首次將生物膜基質成分與氧微環境、生物學耐受性三者定量關聯,為工程化生物膜的設計奠定了方法論基礎。